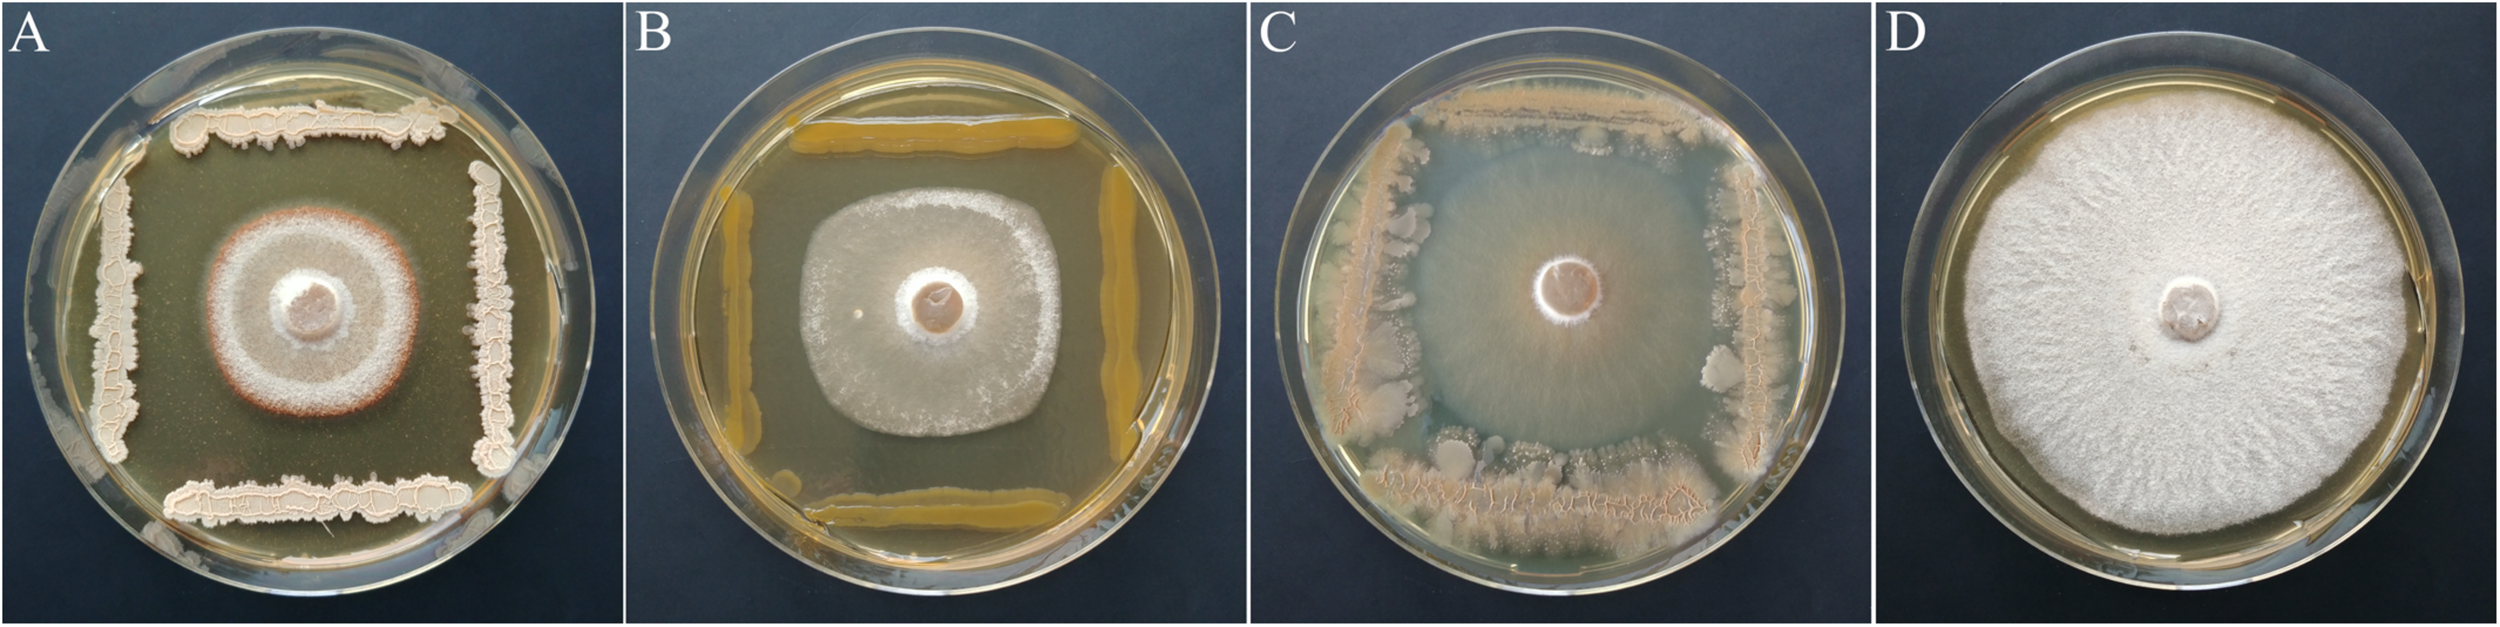
FIGURE 7

Abstract
In the last few years, the alarming spread of Hymenoscyphus fraxineus, the causal agent of ash dieback, has resulted in a substantial threat to native ash stands in central and northern Europe. Since leaves and leaf petioles are the primary infection sites, phyllosphere microorganisms are presumed to interact with the pathogen and are discussed as a source of biocontrol agents. We studied compound leaves from susceptible and visible infection-free trees in four ash stands with a high likelihood of infection to assess a possible variation in the bacterial microbiota, depending on the health status of the trees. The bacterial community was analyzed by culture-independent 16S rRNA gene amplicon sequencing and through the isolation and taxonomic classification of 2,589 isolates using matrix-assisted laser desorption/ionization time-of-flight mass spectrometry (MALDI-TOF MS). The bacterial community structure did not show significant differences. However, a set of amplicon sequence variants (ASVs) and MALDI groups belonging to Luteimonas, Aureimonas, Pseudomonas, Bacillus, and Paenibacillus were distinctly increased in tolerant trees, which may be associated with the ability of the tree to resist the pathogen. The most obvious differences were observed for Luteimonas, a genus that is also exclusively present in the healthy core microbiome. In a first in vitro screen of antagonists, approximately 11% of total isolates suppressed the growth of H. fraxineus, but a statistical test with two different H. fraxineus strains confirmed only the antagonistic activity of 8% of these isolates. The antagonistic isolates were assigned to Bacillus velezensis, Pantoea vagans, and Pseudomonas caspiana. Overall, our study provides a set of isolates or phylogenetic groups that might be involved in the process that prevents the penetration and spread of H. fraxineus. In the next step, in planta experiments are required with a longer period of exposure to H. fraxineus to evaluate effective isolates or consortia of isolates acting through direct antagonism or competition or indirectly by inducing resistance.
Introduction
Starting in northeastern Poland in the early 1990s, the severe dieback of common ash (Fraxinus excelsior) with a high mortality rate has spread across the European continent and is now present almost throughout the entire natural distribution range of European ash (Kowalski and Holdenrieder, 2009a; McKinney et al., 2014; Vasaitis and Enderle, 2017). The causal agent of ash dieback is the invasive ascomycete fungus Hymenoscyphus fraxineus (T. Kowalski) (Baral et al., 2014). This pathogen is considered to originate from Asia, where it is reported to have an asymptotic association with Fraxinus mandshurica and Fraxinus chinensis ssp. rhynchophylla (Zhao et al., 2013; Cleary et al., 2016). In Europe, it is killing ash at an alarming rate and displacing the non-aggressive indigenous fungus Hymenoscyphus albidus (Drenkhan et al., 2017).
Less than 5% of trees are partially resistant or tolerant to ash dieback disease, and trees of all ages are affected at various site types in forest, urban, and nursery settings (Timmermann et al., 2011; McKinney et al., 2014). While young trees often die within a few years after infection, older trees generally become chronically diseased and more susceptible to root rot diseases caused by Armillaria spp. (Skovsgaard et al., 2010; Langer et al., 2015; Chandelier et al., 2016).
The infection of leaves by H. fraxineus derives from the windborne ascospores produced between June and September in sexual fruiting bodies (apothecia) that are mainly growing on the petioles of ash leaves that have fallen from infected trees after overwintering on soil debris (Queloz et al., 2011). H. fraxineus behaves as a necrotrophic pathogen. The ascospores germinate on the leaf surface and leaf petioles. After penetrating the cuticle and the epidermis by forming appressoria, the fungus causes dark brown/orange lesions on leaflets, which then expand proximally and spread into petioles (Hanackova et al., 2017b). After crossing the petiole–shoot junction, the pathogen may also spread into shoots and twigs, causing necrotic bark lesions. Xylem vessels are occluded, and as branches are girdled by lesions in the cambium, the crown starts dying back. However, shoot infection is the endpoint in the life cycle of H. fraxineus because fructification only very rarely occurs on dead stems (Gross et al., 2014). The loss of leaves in the crown of mature trees proceeds over several years and leads to tree death in severe cases (Cleary et al., 2013; Gross et al., 2014; McKinney et al., 2014). The fungus overwinters among the leaf litter, where it undergoes an extensive saprophytic stage. In early summer, new apothecia appear on the pseudosclerotial leaf rachises, mostly on petioles from the previous year (Kowalski and Holdenrieder, 2009b; Gross et al., 2014) and fire ascospores up into the air (100,000 ascospores per cubic meter were found in infected areas). These ascospores are distributed widely by the wind (Hietala et al., 2013; Chandelier et al., 2014) and carried to ash leaves to complete the life cycle (Gross et al., 2012).
Since leaves and leaf petioles are the primary infection sites for establishing new infections on trees (Cleary et al., 2013; Schwanda and Kirisits, 2016) and H. fraxineus is able to complete its entire life cycle on ash leaves, the pathogen might be hampered by bacteria and fungi colonizing leaf surfaces or living inside the leaves (Cross et al., 2017; Hanackova et al., 2017a; Schlegel et al., 2018).
Several studies have explored the composition of fungal communities in F. excelsior leaves and shoots (Unterseher et al., 2007; Davydenko et al., 2013; Kosawang et al., 2018; Schlegel et al., 2018). Seasonal, site-specific, and vertical changes were observed in the identified fungal communities (Scholtysik et al., 2013; Cross et al., 2017; Hanackova et al., 2017a), but distinct differences in the fungal communities on leaves of F. excelsior trees with and without dieback symptoms were not detected (Griffiths et al., 2020). According to Schlegel et al. (2016), ash leaf-inhabiting fungal endophytes produce antifungal secondary metabolites that inhibit the germination of H. fraxineus ascospores ex situ. Furthermore, fungal endophytes with a high antagonistic activity against H. fraxineus in vitro and the potential to serve as biological control agents against ash dieback were isolated (Junker, 2013; Schulz et al., 2015; Hanackova et al., 2017a; Kosawang et al., 2018).
Although communities of fungal endophytes and epiphytes inhabiting F. excelsior leaves are well studied, very little is known about the bacterial community of common ash and how the bacteria interact with the pathogen H. fraxineus. Recently, Griffiths et al. (2020) analyzed the bacterial community structure of F. excelsior leaves in the United Kingdom but did not observe a significant effect of the H. fraxineus infection. They identified a small proportion of genera negatively correlated with the intensity of the H. fraxineus infection. However, studies of culturable bacteria and their antagonistic potential toward H. fraxineus are still lacking.
Bacteria directly attack fungal pathogens by secreting antibiotic compounds, including heterocyclic phenazines (Mavrodi et al., 2006) and cyclic lipopeptides (Ongena et al., 2007) or hydrogen cyanide as a volatile compound that acts directly on cells by blocking cytochrome c oxidase. The production of extracellular hydrolytic enzymes has an important role in degrading the cell wall polymers of fungal plant pathogens (Wu et al., 2018). However, the fungal pathogen is also suppressed through competitions for resources such as nutrients or space (e.g., by siderophores), niche colonization, blockage of the potential entry points of the pathogen, or prevention of the germination of its propagules, as well as indirectly through the induction of systemic resistance (Terhonen et al., 2018; Schlechter et al., 2019). Due to their protective effects, plant-associated bacterial isolates represent potential biocontrol agents in a number of trees (Brooks et al., 1994; Barriuso et al., 2008; Melnick et al., 2011; Prieto et al., 2011). In the last few years, research examining the correlation between bacteria and fungi with plant health has shifted from single strains or species to a more community-based view that focuses on microbiomes (Berg et al., 2017; Köberl et al., 2017; Witzell and Martin, 2018). Koskella et al. (2017) reported a link between the community composition of bark-associated bacteria and symptoms of bleeding canker in Castanea dentata, suggesting that the tree microbiota affected the spread of the disease.
In addition to stochastic colonization, active recruitment of useful microbial communities (Muller et al., 2016; Lemanceau et al., 2017; Hamonts et al., 2018) is presumed to be an operational mechanism for shaping the microbiota of long-living trees (Witzell and Martin, 2018). Other factors are also known to modulate the plant microbiota, including local conditions, plant age and fitness, climate, and pathogen presence (Compant et al., 2019). Accordingly, bacteria specific for the leaves of tolerant ash trees in severely affected stands may be associated with the ability of the tree to resist the pathogen or are potentially involved in protecting the host from ash dieback. Therefore, in this study, ash trees with visible symptoms of ash dieback were compared with healthy-looking trees, which were recorded as having a relatively high tolerance to H. fraxineus. We hypothesize that significant differences in the bacterial leaf microbiome exist, and the comparison of these trees will reveal bacteria that are capable of suppressing the pathogen. A high-throughput sequencing approach is combined with cultivation methods to analyze the microbiome as completely as possible and to overcome the biases of both procedures. We further assume that plant-associated bacteria adapted to ash trees are a reservoir for isolates with antagonistic potential. The ability to directly attack the fungal pathogen is tested in vitro by performing dual-culture assays.
Materials and Methods
Study Site and Sampling Strategies
Field sampling was conducted in July 2017 at four ash forest districts in Northeast Germany with a severe infestation of H. fraxineus infection: Lendershagen (54°23′N, 12°83′E; plot A), Karnin (54°26′N, 12°87′E; plot B), Pennin (54°25′N, 13°E; plot C), and Wredenhagen (53°30′N, 12°58′E; plot D). In each of the districts, four pairs of adjacent trees consisting of a susceptible and a tolerant individual (age between 60 and 80 years) were selected. The distance between the tree pairs within the districts was at least 80 m. Healthy trees were very rarely observed in the long-term monitoring plots and were previously recorded as having relatively high tolerance to ash dieback because they had grown in a site where the pathogen has been present for several years (Sündermann and Jütte, 2014). Compound leaves with petioles from healthy trees were sampled by shooting down branches using a catapult; diseased trees were cut down to sample the leaves. Representative samples were collected from the middle part of the crowns from both healthy and susceptible trees. To exclude the effect of the pathogen H. fraxineus on the indigenous microbial community, visually healthy leaves and petioles were sampled from both susceptible and tolerant trees. Altogether, samples from 32 trees were collected and stored in plastic bags at 4°C for transportation and processed within 24 h.
In the laboratory, leaves, leaflets, petioles, and rachis were randomly chosen from compound ash leaves. An aliquot of the samples (4 g) was ground in 4 ml of sterile 0.85% NaCl with a sterile mortar and pestle and used for cultivation. Another aliquot of the samples (4 g) was ground in liquid nitrogen and stored at −80°C until DNA extraction.
DNA Extraction and Amplicon Sequencing From Ash Leaves
Total DNA was extracted from 100 mg of the ground plant material using the DNeasy Plant Mini Kit (Qiagen, Hilden, Germany). The cells were disrupted again with the FastPrep-24 Instrument (MP Biomedicals, Germany; 30 s at 6 ms–1), and extraction was performed using a standard protocol. The degree of DNA degradation was monitored on 1% agarose gels. The DNA purity and concentration were measured using a NanoDrop spectrophotometer. The V5–V6 region of the 16S rRNA genes was amplified using the primers 799F and 1115R, which exclude the chloroplast and mitochondria DNA of the host plant (Chelius and Triplett, 2001; Redford et al., 2010). The primers contained a heterogeneity spacer along with a barcode sequence. The amplicons were purified with a MSB Spin PCRapace kit (Invitek, Berlin, Germany) and mixed at equimolar DNA concentrations. Library preparation and Illumina MiSeq 300-bp paired-end sequencing was performed at LGC Genomics (Berlin, Germany).
Data Processing and Statistical Analysis
The raw sequence data were processed with the DADA2 R package v. 1.12.1 (Callahan et al., 2017) and mothur v. 1.39.1 (Schloss et al., 2009; RRID: SCR_011947). The DADA2 algorithm was applied for quality filtering and removing chimeric sequences. Based on a parametric error model, the pipeline provides amplicon sequence variants (ASVs), in contrast to the traditional operational taxonomic unit (OTU) approach, and reduces the problem of falsely identified OTUs originating from mis-clustered sequences (Fricker et al., 2019). The ASVs were taxonomically assigned by the naive Bayesian classifier method using the Silva reference database v. 132 (RRID: SCR_006423). In addition, the assignment was completed at the species level if the ASVs exactly matched the sequence of the reference strain of only one species. The taxonomic assignment was confirmed with the taxonomic classification in mothur using the RDP training set 16 (RRID: SCR_006633) and the Silva database. Statistical analyses were performed using the phyloseq, vegan, and ape packages of R 3.6.0, as well as MicrobiomeAnalyst (Chong et al., 2020; RRID: SCR_015022). All samples were rarefied to the minimum number of sequences among all samples. Three diversity indices (Chao 1, Shannon, and Simpson) were calculated. The community structure was compared by applying a principal coordinate analysis (PCoA) based on an unweighted UniFraq distance matrix of the ASVs. Significant differences between the bacterial communities were tested using analysis of similarity (ANOSIM). A taxonomic network was constructed using Cytoscape version 3.7.1 to visualize differences in the core microbiome (Shannon et al., 2003; RRID: SCR_003032). The differential abundance at different taxonomic levels was analyzed with the metagenomeSeq tool using the false discovery rate (FDR) for multiple test correction (Paulson et al., 2013).
The paired sequence reads were deposited in the public repository Sequence Read Archive (SRA, RRID: SCR_004891) with the accession number PRJNA602193.
Isolation of Bacteria
For the isolation of epiphytic and endophytic bacteria, the ground plant material from each sample was serially diluted in 0.85% NaCl and plated on R2A, a nutrient-poor medium that is suitable for the growth of diverse plant-associated bacteria (Difco, Detroit, United States). Plates were incubated at 25°C for at least 7 days. Population densities were determined by counting the colony-forming units (CFU), and the results are reported as CFU per gram of fresh weight. Approximately 80 isolates per sample were randomly selected from R2A, purified by streak dilution and stored at −80°C in nutrient broth containing 40% glycerol until further processing.
Dereplication and Phylogenetic Classification of Epiphytic and Endophytic Isolates
Matrix-assisted laser desorption/ionization time of flight mass spectrometry (MALDI-TOF MS) was used as an approved high-throughput method for the dereplication and classification of bacteria in large environmental studies (Huschek and Witzel, 2019). Prior to measurement, bacterial isolates were freshly inoculated on CASO broth (Fluka, Buchs, Switzerland) solidified with 15 g L–1 agar and cultivated for 24 h at 25°C. The whole-cell measurement protocol was used to obtain mass spectra. Briefly, ∼0.1 mg of cell material was transferred directly from the edge of a bacterial colony to a MALDI target spot. After drying at room temperature, sample spots were overlaid with 1 μl of matrix solution (Bruker Daltonics, Bremen, Germany). The MS analysis was performed with a MicroflexTM LT/SH MALDI-TOF mass spectrometer (Bruker Daltonics) using Flex Control 3.4 software, as described in detail by Müller et al. (2016). The MALDI Biotyper Preprocessing Standard Method and the MALDI Biotyper MSP Identification Standard Method were used for bacterial classification with Biotyper 3.1 software equipped with the MPS Library (release August 2018), according to the manufacturer’s instructions (Bruker Daltonics). Isolates with a score value greater than 2.3 (highly probable species identification) were considered as identified by the Bruker database. The spectra of the isolates with lower scores were compared with each other and grouped based on a score > 2.3. Representative strains of the unidentified groups were taxonomically classified by sequencing almost the complete 16S rRNA gene. Briefly, total DNA was extracted from single colonies by resuspending them in 20 μl of 25 mM NaOH/0.25% SDS and incubating the mixture for 15 min at 95°C. The 16S rRNA gene was amplified using primers 8f and 1525r (Lane, 1991) according a protocol described by Ulrich and Wirth (1999) and sequenced with the internal primers 1492r (Lane, 1991) and 782r (Chun and Goodfellow, 1995) or 926r (Liu et al., 1997). All reference strains were unambiguously taxonomically assigned at the genus level with mothur using the RDP database. For a further phylogenetic classification, the closest related species were determined using EzBioCloud (Yoon et al., 2017). After supplementing the MALDI BiotyperTM database with the spectra of the reference strains, a reliable taxonomic identification of all isolates was achieved using the results of the MALDI-TOF MS analysis. The MALDI groups were designated with respect to the assigned reference strain. If several groups of the same bacterial species were identified, the groups were consecutively numbered. For groups assigned to one of our reference isolates, the species name is reported in quotation marks and represents the most closely related species (Supplementary Table S1).
The Pseudomonas MALDI groups were subjected to a further phylogenetic analysis using a multi-locus sequence analysis (MLSA). The housekeeping genes gyrB, rpoB, and rpoD were chosen for this purpose and amplified and sequenced as described by Mulet et al. (2010). Together with the 16S rRNA gene, a concatenated tree was constructed. The alignment comprised 1,432 bp of 16S rRNA, 1,088 bp of gyrB, 1,111 bp of rpoB, and 716 bp of rpoD gene. The total length of the alignment was 4,347 bp.
For the statistical analysis, the number of isolates per sample was normalized using the CSS method (Paulson et al., 2013). Significant differences in the community composition between tolerant and susceptible trees were tested by the MetagenomeSeq tool (MicrobiomeAnalyst, PFDR < 0.05).
The 16S rRNA gene sequences of the reference isolates of the MALDI groups were deposited in NCBI (RRID: SCR_006472) under the accession numbers MN989032–MN989182.
In vitro Screening and Statistical Analysis of Antagonistic Activity Toward H. fraxineus
All bacterial isolates were screened for their antagonistic activity toward H. fraxineus isolate P3 using a cocultivation assay described by Pane and Zaccardelli (2015). Briefly, an agar plug (ø 5 mm) with H. fraxineus mycelium was placed in the center of the petri dish, while four bacterial isolates were spread around the edge of the plate. Plates containing the H. fraxineus mycelium alone were used as control. The test was performed on PDA medium enriched with ash shoot extract (30 g of ash leaves per liter of PDA) at 22°C. Due to its slow growth, H. fraxineus was inoculated 5–6 days before the bacteria. The antifungal activity was monitored by measuring the fungal colony radius (r) after 1 and 2 weeks until the control reached the edge of the plate. The inhibition of H. fraxineus was estimated using the following formula: percent growth inhibition = 100 × [(rcontrol − rcocultivation) ÷ rcontrol]. Isolates with inhibition rates >30% were chosen for a subsequent statistical assay (three replicates) with two H. fraxineus isolates (P3 and HF23). In this approach, each bacterial isolate was tested on a separate plate by spreading it around the fungus four times. The statistical test was also used to evaluate the vitality of the residual H. fraxineus mycelium after confrontation with the bacteria. For this purpose, agar plugs (ø 5 mm) of the mycelium were picked and incubated on PDA with the ash shoot extract. The growth of the fungus was assessed after 2 weeks by estimating the mycelium diameter and comparing it to the untreated control.
Two-year-old ash seedlings were inoculated with either isolate using an approach described by Przybyl (2003) to verify the pathogenicity of the H. fraxineus isolates. The symptoms were monitored for 8 weeks, and the virulence of both isolates could be confirmed.
Results
Comparison of the Bacterial Community Structure by Amplicon Sequencing of the 16S rRNA Gene
The V5–V6 region of the 16S rRNA gene from the microbiomes of 16 tolerant and 16 susceptible trees was amplified with primers that exclude the host plant DNA. An evaluation of the Illumina sequence reads revealed an exceedingly high abundance of the genera Bacillus (93%) or Escherichia and Pseudomonas (89%) in the samples B2K and A1K (from susceptible trees), respectively, suggesting that these samples were contaminated. Both samples were excluded from the analyses. After quality filtering and removing potential chimeras and plastid and mitochondrial sequences from ash trees, 3,562,425 high-quality sequences were obtained that formed 3,634 ASVs with an average of 413 ASVs per sample. Sequences rarefied to 44,537 reads per sample were used as input for all subsequent analyses.
Alpha diversity estimates such as the Shannon index showed no significant differences, with values of 4.02 ± 0.34 (mean ± SD) for susceptible trees and 4.03 ± 0.35 for tolerant trees. The analysis of the beta diversity resulted in small but significant differences between the bacterial community structure grouped by forest plot and health status (ANOSIM R = 0.2118, P < 0.001). The differences are shown in Figure 1. The first axis indicated some differences between tolerant and susceptible trees, particularly in plot D. However, the pairwise comparisons did not result in any significant differences.
FIGURE 1

Ordination plot showing the differences in the community structures of tolerant (t) and susceptible (s) trees across the four sampled forest districts (A–D). A principal coordinate analysis (PCoA) was applied based on the unweighted UniFraq distance matrix.
The taxonomic assignment of ASVs revealed 10 taxa at the phylum level. The phylum Proteobacteria predominated across all samples (with a mean of 58%). Within the Proteobacteria, α-Proteobacteria were the most abundant class, representing 40% of the total sequences, followed by γ- and β-Proteobacteria at 9 and 6%, respectively. Other abundant phyla were Bacteroidetes (20%), Actinobacteria (17%), and Deinococcus–Thermus (3%). Firmicutes accounted for only 0.33% of ASVs among all samples. Only 1.8% of the total sequences were unable to be assigned to bacterial taxa. The results revealed a high phylogenetic diversity of leaf bacteria, with 241 taxa identified at the genus level. Sphingomonas (18.4%), Hymenobacter (16%), and bacteria of the order Rhizobiales (8.7%) dominated the total bacterial community. Other abundant genera were Methylobacterium (5.4%), Pseudomonas (3.2%), Deinococcus (3.0%), and Massilia (2.7%).
Comparing the bacterial microbiomes of tolerant and susceptible trees at the phylum level, Firmicutes was significantly (threefold) increased in tolerant F. excelsior (PFDR = 0.05). At the class level, γ-Proteobacteria were present at significantly higher levels in tolerant plants (PFDR = 0.046) and were particularly enriched with sequences associated with bacteria of the family Xanthomonadales (PFDR = 0.0016) and the genus Luteimonas (PFDR = 3.9E-06). Five abundant phylotypes (>0.3%) were significantly increased in tolerant trees at the genus level. Luteimonas showed a 15-fold increase, Halomonadaceae sp. a 3.8-fold increase, Microbacterium a 2.6-fold increase, Aliihoeflea a 27-fold increase, and Agrococcus a 2.2-fold increase. Some other genera, such as Aureimonas, were also present at higher levels (3.7-fold) in tolerant trees, but the difference was not significant.
The leaf core microbiome was determined at the genus level and defined as those taxa that were present in at least 75% of the respective samples. It included 37 abundant bacterial taxa (greater than 0.1%) for the tolerant F. excelsior trees, which represent 87.1% of all sequences. Susceptible plants contained only 30 genera in their core microbiome (88.2% of the total sequences). The comparison of the core microbiomes of tolerant and susceptible ash trees is illustrated using a clustering network (Figure 2). Twenty-eight taxa shared both core microbiomes, including the predominant genera Sphingomonas and Hymenobacter. Nine genera from three different phyla were specific to the tolerant trees, with the highest abundance observed for Luteimonas and Chryseobacterium. Two genera were detected only in susceptible trees. Overall, the specific bacteria for trees with each health status were less abundant than the shared microbiota.
FIGURE 2

Core microbiomes of susceptible and tolerant F. excelsior leaves at the genus level. The core microbiomes (taxa occurring in 75% of all replicates of each group that exhibited at least 0.1% abundance in the community) were combined for the network analysis. The size of nodes corresponds to the relative abundance in the whole dataset, node labels display their taxonomic affiliation, and the color of the nodes indicates the respective phylum.
Based on ASVs, bacterial communities of tolerant and susceptible trees were compared using a differential abundance analysis. Figure 3 presents an overview of ASVs that were significantly increased in tolerant ash trees. ASV0013, which was identified as Luteimonas sp., was remarkably increased in tolerant trees. Several ASVs from other genera were increased; for instance, seven ASVs of the genus Pseudomonas and two ASVs of Aureimonas showed a significantly higher abundance in tolerant trees.
FIGURE 3

Overview of significantly increased amplicon sequence variants (ASVs) in tolerant F. excelsior trees. The ASVs are arranged according their abundance (>0.07%). Statistical significance (PFDR) is indicated in brackets.
Comparison of the Culturable Bacterial Communities of Susceptible and Tolerant F. excelsior Trees
Population densities of culturable bacteria in F. excelsior leaves and petioles ranged from 5 × 104 to 8 × 105 CFU g–1 fresh weight. Significant differences were not observed between tolerant and susceptible trees.
The 2,589 bacterial isolates derived from the 32 samples represent the common culturable epiphytic and endophytic bacterial communities from the leaves of susceptible and tolerant F. excelsior trees. The isolates were classified into 166 phylotypes (MALDI groups) belonging to 45 genera (Supplementary Table S1). At the phylum level, the culturable ash-associated bacteria were dominated by Proteobacteria (81%), followed by Actinobacteria (14%) and Firmicutes (5%). Proteobacteria were mainly represented by α- and γ-Proteobacteria at 47% and 33%, respectively. In the comparison of tolerant and susceptible trees, the amount of Proteobacteria was the same, whereas the proportions of Actinobacteria (11% to 18%) and Firmicutes (9% to 1%) were different to some extent, as the latter was significantly increased in tolerant plants (PFDR = 0.0044). Regarding the bacterial classes, γ-Proteobacteria (37 to 29%, PFDR = 0.022) and Bacilli (9 to 1%, PFDR = 0.021) were present at significantly higher levels in tolerant trees.
At the genus level, Sphingomonas and Pseudomonas dominated the culturable bacterial community of ash trees at 33 and 20%, respectively, followed by Curtobacterium, Xanthomonas, and Rhizobium each with 6% and Frigoribacterium and Luteimonas with 4%. The relative abundance of bacterial genera in trees differing in health status is shown in Figure 4. A comparison of bacterial communities revealed a significantly higher proportion of isolates in tolerant trees for the abundant genera Luteimonas (24-fold), Paenibacillus (7-fold), and Aureimonas (46-fold), as well as genera occurring at lower percentages, such as Staphylococcus, Pseudoxanthomonas, and Rhodobacter.
FIGURE 4

Structure of the culturable bacterial communities in tolerant and susceptible F. excelsior trees. Genera with significantly increased abundance in tolerant trees are highlighted in green. The analysis is based on the classification of 2,589 isolates (16 replicates).
A differential abundance analysis was performed at the level of MALDI groups to identify groups of isolates specific for tolerant trees that may be associated with the ability of the tree to resist the pathogen (Figure 5). In tolerant trees, the Luteimonas MALDI group was increased more than 20-fold. Additionally, other groups, such as Aureimonas “altamirensis,” Paenibacillus “lautus” 2, Pseudomonas flavescens, Sphingomonas “glacialis” 3, and Bacillus “firmus” 2, showed a distinctly higher abundance in the culturable bacterial community of tolerant trees. Of the four Methylobacterium “bullatum” MALDI groups, three groups were significantly increased in tolerant trees.
FIGURE 5

MALDI groups of bacterial isolates with a significantly higher abundance in tolerant trees. Groups displaying significant increases are sorted according to their abundance. The level of significance is indicated in brackets (PFDR, MetagenomeSeq). Species names enclosed in quotation marks were assigned based on 16S rRNA gene sequencing. Similarity values to the closest relative type strains are shown in Supplementary Table S1.
The genus Pseudomonas is particularly interesting among bacteria that are able to inhibit the activity of pathogenic fungi. It was the second-most abundant genus in the culturable bacterial community of ash leaves. In tolerant trees, the proportion of pseudomonads was slightly increased (22.6%) compared to that in susceptible trees (17%). Altogether, 497 Pseudomonas isolates were obtained from the 32 leaf samples and classified into 13 MALDI groups belonging to five different species groups (Pseudomonas lutea, Pseudomonas rhizosphaerae, Pseudomonas syringae, Pseudomonas fluorescens, and Pseudomonas straminea) within the P. fluorescens lineage (Mulet et al., 2010; Peix et al., 2018). For a more precise differentiation of the species groups, at least one representative isolate was chosen from each MALDI group to perform a MLSA (Figure 6). The analysis focused on Pseudomonas coleopterorum and Pseudomonas graminis because they contained the largest numbers of isolates (179 and 114, respectively). Eight of the 13 MALDI groups were clearly assigned to five distinct Pseudomonas species. In addition to P. flavescens and Pseudomonas cerasi, two MALDI groups were each classified into P. coleopterorum, P. graminis, and Pseudomonas caspiana. In contrast to the phylogenetic analysis based on the 16S rRNA gene, the Pseudomonas “congelans” group (isolate C4P022b) was located close to the P. syringae-type strain in the concatenated tree. Similarly, the Pseudomonas “extremaustralis” group (isolate A4K089) was more closely assigned to Pseudomonas poae and Pseudomonas trivialis than to the P. extremaustralis-type strain using MLSA. Three MALDI groups [Pseudomonas “moorei” (D4P040), P. “rhizosphaerae” (C4K059), and P. “caspiana” 1 (B1K012)] did not clearly cluster with any Pseudomonas strain, suggesting that these groups probably represent new species. Overall, the MALDI classification and MLSA result in a similar differentiation at the species level. Within a species, namely, P. caspiana, the differentiation corresponds to the MALDI groups. For P. graminis and P. coleopterorum, the intraspecies differentiation was not consistent between the two methods.
FIGURE 6

Phylogenetic tree of representative strains for the Pseudomonas MALDI groups in relation to respective type strains of the genus. The tree is based on the analysis of partial sequences of four concatenated genes (16S rRNA, gyrB, rpoB, and rpoD; accession numbers/locus tags are listed in Supplementary Table S2). The dendrogram was generated with the maximum likelihood algorithm based on the general time-reversible substitution model with G + I. Numbers at branch nodes refer to bootstrap values >70%. Bar, 0.01 substitutions per nucleotide site. The designation of MALDI groups was only based on 16S rRNA gene similarity. Pseudomonas species groups were indicated as proposed by Peix et al. (2018).
Antagonistic Potential of Bacterial Isolates – Growth Inhibition of H. fraxineus
The bacterial isolates were screened for their ability to inhibit the growth of H. fraxineus using cocultivation assays as a method to detect putative antagonists. The screen produced 282 isolates (10.9% of the total isolates) that suppressed pathogen growth by at least 30%. In some cases, the inhibitory effect was combined with the lysis of the mycelium. The antagonistic isolates were obtained in the same proportions from tolerant and susceptible trees and mainly belonged to the genera Sphingomonas (38%) and Pseudomonas (21%). A series of other genera (18) from three different phyla, such as Xanthomonas, Microbacterium, and Paenibacillus, was present at comparably low proportions (1–7%, Supplementary Figure S1). Isolates of the genera Pantoea and Bacillus showed the highest mean growth inhibition rates (∼40%).
Based on the primary screen, 78 isolates were assayed for their antagonistic activity with a statistical cocultivation test using three replicates and two H. fraxineus strains. Both isolates were confirmed to be virulent on young ash trees, whereas H. fraxineus P3 was more susceptible in cocultivation tests than HF23 (Supplementary Table S3). The evaluation was completed by testing the vitality of the remaining fungal mycelium after confrontation with the bacteria. An overview of the activity of isolates from all tested MALDI groups is shown in Table 1. In general, the test confirmed the results of the screen, although several isolates, including members of the genus Luteimonas, failed in the statistical test. Of the 78 isolates, six strains significantly inhibited the growth of both H. fraxineus isolates, whereas 17 strains only affected P3 and eight only inhibited HF23 (Supplementary Table S3). The strongest effects were observed for Bacillus “velezensis” A4P130, Pantoea “vagans” B3K066, and P. “caspiana” B1P055, with growth inhibition rates ranging from 41 to 55%. In particular, cocultivation with A4P130 resulted in the formation of a sharp necrotic zone along the edge of the mycelium of H. fraxineus P3 (Figure 7). However, the mycelium picked outside of this zone remained viable. The isolates B3K066 and B1P055 exerted a dramatic effect by lysing the fungal mycelium during cocultivation. Accordingly, isolate P3 was completely killed, and the less susceptible isolate HF23 showed a visible reduction in vitality (Table 1). A clear antagonistic activity was also observed for Bacillus “tequilensis” C4K066b and Erwinia “billingiae” D4P109. These bacteria were weaker in their ability to immediately suppress fungal growth, but they affected the mycelium during cocultivation. For example, the mycelium of H. fraxineus P3 was completely lysed at the end of the confrontation with B. “tequilensis” C4K066b (Figure 7). This lytic effect was less pronounced for HF23, resulting in a relative high mycelium vitality (64%). In contrast, E. “billingiae” D4P109 completely killed both H. fraxineus isolates during cocultivation.
TABLE 1
| Isolatea | Taxonomic assignment | Growth inhibition rate in coculture (%)b | Vitality of the mycelium (% of the untreated control) | ||
| P3 | HF23 | P3 | HF23 | ||
| C4K093 | Achromobacter “denitrificans” | 40.0* | 12.3 | 98.4 | 81.5 |
| A4P130 | Bacillus “velezensis” | 50.6* | 54.7* | 96.3 | 101.7 |
| C4K066b | Bacillus “tequilensis” | 35.1 | 37.5 | 0.0 | 63.9 |
| C4P040b | Bacillus cereus | 30.0 | 35.0 | 98.5 | 91.7 |
| A2K052 | Curtobacterium “flaccumfaciens” 2 | 28.4 | 22.9 | 0.0 | 87.5 |
| D4P109 | Erwinia “billingiae” | 40.0* | 22.5 | 0.0c | 0.0c |
| B3K063 | Frigoribacterium “faeni” 5 | 44.4* | 37.5 | 0.0 | 82.9 |
| D1P082 | Luteimonas “aestuarii” | 22.5 | 25.6 | 64.8 | 86.2 |
| D3P076 | Methylobacterium “bullatum” 1 | 30.0 | 2.4 | 100.0 | 90.7 |
| C4K020 | Methylobacterium “cerastii” | 25.3 | 4.4 | 0.0c | 94.4 |
| D3P082 | Methylobacterium “goesingense” 2 | 30.8 | 6.1 | 96.3 | 90.7 |
| C4K087b | Methylobacterium “pseudosasicola” 2 | 22.1 | 18.8 | 97.1 | 90.3 |
| C1P060 | Microbacterium “hatanonis” 2 | 39.5* | 17.7 | 95.8 | 96.0 |
| D2K023 | Novosphingobium “fluoreni” 4 | 35.0 | 34.6 | 85.9c | 89.8 |
| B3P038 | Paenibacillus “lautus” 2 | 45.7* | 7.3 | 67.6c | 85.5 |
| B3K066 | Pantoea “vagans” | 40.5* | 47.5* | 0.0 | 80.8 |
| B1P055 | Pseudomonas “caspiana” 3 | 41.0* | 43.0* | 0.0 | 86.8 |
| A1P062 | Pseudomonas “cerasi” | 32.1 | 36.7 | 0.0 | 80.5 |
| B2K013 | Pseudomonas “coleopterorum” 2 | 32.1 | 26.8 | 0.0 | 1.9 |
| D4P037 | Pseudomonas flavescens | 6.7 | 6.3 | 27.4c | 92.9 |
| A3P049 | Pseudomonas “graminis” 1 | 29.6 | 17.5 | 0.0c | 87.2 |
| A4K089 | Pseudomonas “extremaustralis” | 31.3 | 21.5 | 0.0c | 92.0 |
| A2P026 | Pseudoxanthomonas “spadix” | 35.0 | 15.7 | 91.5 | 84.4 |
| A2P086 | Rahnella “victoriana” | 33.3 | 26.2 | 0.0 | 97.4 |
| B3P075 | Rhizobium “skierniewicense” | 31.3 | 30.0 | 0.0 | 86.7 |
| B3P008 | Sphingomonas “aerolata” 1 | 36.4 | 32.9 | 0.0c | 100.0 |
| D4P108 | Sphingomonas “taxi” 1 | 22.5 | 35.0 | 98.6 | 100.0 |
| D2K022 | Sphingomonas “aurantiaca” | 37.5 | 30.9 | 76.6c | 95.2 |
| B3K005 | Sphingomonas faeni 1 | 38.7* | 32.9 | 0.0 | 90.3 |
| B4K076 | Variovorax “robiniae” 1 | 26.7 | 26.8 | 96.0 | 88.7 |
| A4P033 | Xanthomonas “cynarae” | 44.4* | 28.9 | 0.0 | 81.0 |
Antagonistic activity of isolates from different MALDI groups assessed by the ability to inhibit the growth of H. fraxineus and vitality test of the remaining fungal mycelium.
aOf the 78 tested bacteria, only one typical or the best isolate from each MALDI group is listed. Details are provided in Supplementary Table S2. bGrowth inhibition was tested using the H. fraxineus isolates P3 and HF23. *Significantly increased compared to a control Pseudomonas sp. PI01 (culture collection Thünen Institute, Waldsieversdorf, Germany) that did not show antagonistic activity in cocultures (growth inhibition rates: 4.0 and 8.5). The test was performed using the Kruskal–Wallis one-way analysis of variance on ranks followed by pairwise comparisons with Dunn’s test (P < 0.05). cDetection of the antagonistic isolate inside the recovered H. fraxineus mycelium or instead of the mycelium.
FIGURE 7
Inhibition of H. fraxineus P3 growth by cocultivation with B. “velezensis” A4P130 (A), P. vagans B3K066 (B), and B. tequilensis C4K066b (C). The growth of H. fraxineus P3 without cocultivation served as the control (D).
Discussion
In ash dieback, which is caused by H. fraxineus, leaflets and petioles are the main entry point for the pathogen (Cleary et al., 2013; Hanackova et al., 2017b). During and directly after invasion and penetration of epidermal tissue, that is, during the biotrophic phase of the pathogen, endophytic and epiphytic microorganisms in both the leaf and the petiole might be able to inhibit the progression of the pathogen (Cross et al., 2017; Hanackova et al., 2017b; Mansfield et al., 2018). Therefore, microorganisms colonizing the compound leaves have the potential to function as biocontrol agents against H. fraxineus. Numerous studies have examined the association of fungi with H. fraxineus infections. However, studies of bacteria colonizing F. excelsior are rather rare, although bacteria are estimated to be the most abundant and diverse colonists of the leaf phyllosphere. In our study, population densities of up to 8 × 105 CFU g–1 leaf were observed, which are in the same range as the values measured by Weyens et al. (2009). We analyzed endophytic and epiphytic bacteria using a combined approach based on the assumption that both groups may interact with the pathogen in a similar manner. In the phyllosphere, microbes are often observed both as epiphytes on the plant surface and as endophytes within plant tissue (Whipps et al., 2008; Hardoim et al., 2015; van Overbeek and Saikkonen, 2016). Many bacteria have the ability to switch between endophytic and free-living lifestyles and may help protect the plant from inside the leaves and from the leaf surface (Hardoim et al., 2008). Thus, in this context, the distinction between the two habitats appears arbitrary.
Bacterial communities in the ash phyllosphere were dominated by Proteobacteria, Bacteroidetes, and Actinobacteria, which have also been reported to be the dominant phyla in the phyllosphere of F. excelsior plants in the United Kingdom (Griffiths et al., 2020), as well as in other plants (Muller et al., 2016). In studies exclusively analyzing epiphytic bacteria in the phyllosphere of a number of trees, α-Proteobacteria dominated the bacterial community, consistent with our results (Redford et al., 2010; Laforest-Lapointe et al., 2016). Likewise, the proportion of Firmicutes was very low. An analysis of exclusively endophytic bacteria revealed a higher abundance of γ-Proteobacteria and Firmicutes (Hardoim et al., 2015).
At the genus level, similar to other woody plants such as poplar and grapevine, the microbiome of F. excelsior leaves was dominated by Sphingomonas and Hymenobacter (Leveau and Tech, 2011; Crombie et al., 2018). Aydogan et al. (2018) postulated that these genera may represent “hub” taxa that are very important for the microbiome structure and plant–pathogen interactions. In addition to Sphingomonas, isolates of the genus Pseudomonas dominated the culturable bacterial community in our study, while their proportions were very small among the ASVs. This finding indicates the importance of using classical cultivation methods to complement high-throughput sequencing approaches in studies examining the interaction between pathogens and the plant microbiota.
The main question to be answered in this study was whether differences exist in the microbiota of tolerant and susceptible trees that may be related to the severity of ash dieback. In the last few years, research examining the correlations between microorganisms and plant health has increased in importance and shifted from single strains and species to a more community-based view (Witzell and Martin, 2018; Schlechter et al., 2019). The identification and comparison of the core microbiomes of tolerant and susceptible trees are considered particularly important to detect key members of the microbial community involved in protecting the plants from pathogens and to estimate the spread of diseases in relation to microbiome interactions (Koskella et al., 2017; Lemanceau et al., 2017; Hamonts et al., 2018; Orozco-Mosqueda et al., 2018). Koskella et al. (2017) identified a link between the community composition of bark-associated bacteria and bleeding canker symptoms caused by P. syringae in horse chestnut, suggesting that tree microbiota are important to regulate the spread of the disease. In whitebark pine, the resistance to the fungal pathogen Cronartium ribicola is associated with microbiome combinations in healthy trees (Bullington et al., 2018). Similarly, interactions between Erysiphe alphitoides, the causal agent of oak powdery mildew, and foliar fungal and bacterial communities have been described for pedunculate oak (Jakuschkin et al., 2016). In the context of ash dieback, no significant differences were observed between the structures of the endophytic fungal communities of trees with and without symptoms using amplicon sequencing and culture-dependent methods (Hanackova et al., 2017a; Schlegel et al., 2018; Kosawang et al., 2019; Griffiths et al., 2020). Consistent with the study by Griffiths et al. (2020), the bacterial microbiome analyzed in our study did also not show a direct association between the health status and the community structure, but a number of bacterial groups were significantly associated with the H. fraxineus infection.
In the comparison of bacteria of tolerant and susceptible ash leaves at the phylum level, Firmicutes was significantly increased in tolerant leaves. Genera of this phylum are well-known potent antagonists and agents functioning in the biocontrol of pathogenic fungi by producing various bioactive metabolites, such as iturins and fengycins, with a strong inhibitory effect on the growth of a wide range of plant pathogens (Emmert and Handelsman, 1999; Ongena et al., 2005; Müller et al., 2015). In particular, isolates of Bacillus spp. are considered the most common groups that induce systemic resistance (ISR) (Vanpeer et al., 1991; Kloepper et al., 2004; Ongena et al., 2007) and prime plant defenses against pathogens (Elsayed et al., 2020). At the class level, γ-Proteobacteria showed a significantly higher abundance in tolerant F. excelsior trees. Consistent with this result, other studies have described γ-Proteobacteria as components of the microbiome of healthy oak and banana plants (Sapp et al., 2016; Köberl et al., 2017).
The most obvious differences at the genus or species level were observed for the γ-Proteobacterium Luteimonas, which was significantly increased in healthy trees using both amplicon sequencing (ASV 15-fold) and cultivation (MALDI group 24-fold). Isolates of this genus have been described as phyllosphere bacteria of different plants (Sun et al., 2012; Comby et al., 2017; Wemheuer et al., 2017). In antagonistic assays designed to identify biological control agents for the management of Fusarium head blight, Luteimonas showed a slight inhibition of pathogen growth (Comby et al., 2017). In our study, the genus Luteimonas was a component of the specific core microbiome of tolerant F. excelsior plants (Figure 2). Consistent with this finding, Köberl et al. (2017) described Luteimonas as part of the “healthy rhizosphere core microbiome” of banana plants in Fusarium oxysporum wilt-infested areas in Central America and as an indicator species of healthy plants.
Similar to Luteimonas, the abundance of Aureimonas was substantially increased in the leaves of tolerant plants (46-fold in the culturable microbiome and 3.7-fold in ASVs), suggesting that this genus might also be involved in the process that protects ash plants from the pathogen. Aureimonas strains were reported to possess antifungal activity against Phytophthora nicotianae in pineapple by González et al. (2017). Some species of this genus have been reported to produce siderophores (Lin et al., 2013), providing the plant with the ability to inhibit the growth of soilborne pathogens due to limited iron levels (Chaiharn et al., 2009), and these proteins also appear to be involved in activation of the ISR against foliar pathogens (van Loon et al., 2008).
Significantly higher amounts of isolates from the genus Paenibacillus were detected in tolerant trees. More specifically, two MALDI groups of P. “lautus” were distinctly increased. Various Paenibacillus species produce antifungal compounds such as iturins and paenimyxin (Chung et al., 2000; Selim et al., 2005) and excrete a variety of cell wall-degrading enzymes (Naing et al., 2014; Yadav and Dubey, 2018). Paenibacillus species are also known to elicit the ISR against pathogenic fungi (Sang et al., 2014; Grady et al., 2016).
In addition to these genera that are probably involved in the plant–pathogen interaction, the analysis revealed MALDI groups or ASVs of other genera, such as Pseudomonas, Bacillus, Methylobacterium, and Sphingomonas, present at a significantly higher abundance in the phyllosphere of tolerant F. excelsior leaves. In particular, Pseudomonas is noticeable because seven ASVs and two MALDI groups were significantly increased in the phyllosphere of tolerant plants. Bacteria of this genus are known to play an important role in the biological control of phytopathogenic fungi due to the production of antifungal metabolites and hydrogen cyanide (Bloemberg and Lugtenberg, 2001; Haas and Defago, 2005; Fouzia et al., 2015). Some species control the growth of pathogens by inhibiting spore germination (Raaijmakers et al., 1995) or by producing extracellular enzymes that lyse components of the fungal cell wall (Compant et al., 2005). In contrast to direct antagonism, different Pseudomonas strains have the capacity to inhibit or suppress the activity of pathogens by eliciting resistance pathways in the host plant (Bakker et al., 2007).
In the core microbiome, the Bacteroidetes member Chryseobacterium and several actinobacterial genera, such as Microbacterium, were also specific for tolerant ash trees (Figure 2). These genera are known not only for their abilities to promote plant growth but also as biocontrol agents targeting fungal pathogens (Borah et al., 2018; Sang et al., 2018).
Overall, the comparison of the microbiota of F. excelsior leaves revealed several bacterial groups that are specific for tolerant trees, such as Luteimonas, Aureimonas, Pseudomonas, Bacillus, and Paenibacillus, suggesting that some of these genera might be involved in the process that prevents the penetration and spread of the H. fraxineus.
The drivers for the differences between the microbiomes of tolerant and susceptible plants are not yet known. Besides stochastic colonization, long-living trees seem to be able to actively recruit useful microbial communities (Witzell and Martin, 2018). So the plant genotype could indirectly mediate the resistance toward the pathogen. However, other factors or a combination of both might be responsible for shaping the microbiota as well.
A screen against H. fraxineus was performed to identify antagonistic bacteria for use in subsequent in planta assays. One tenth of the total isolates suppressed the growth of H. fraxineus in the screen, but the antagonistic activity was confirmed in a statistical test for only a small proportion (approximately 1–2%) of the total isolates. Comparable studies of the antagonistic effects of bacteria toward H. fraxineus have not been published to date. Among the culturable fungal community, a large percentage of endophytes, particularly fast-growing isolates, inhibited the pathogen (32 or 75%), but, on the other hand, approximately 25% of the fungi were inhibited by H. fraxineus (Schulz et al., 2015; Hanackova et al., 2017a). The inhibition might be due to the production of different fungistatic compounds such as viridin and hymenosetin by the pathogen (Andersson et al., 2010; Halecker et al., 2014). Hymenosetin, a member of the family of 3-decalinoyltetramic acid antibiotics, also exhibited strong activity against gram-positive bacteria, whereas gram-negative bacteria were not affected (Halecker et al., 2014). However, in our cocultivation tests, the growth of the bacterial strains was not inhibited. Strikingly, the H. fraxineus strains P3 and HF23 used in this study displayed extremely different susceptibilities to the bacteria. This difference corresponds to the highly varying capabilities of H. fraxineus strains, including exoenzyme profiles, growth rates, and the production of antibiotics (Halecker et al., 2014; Junker et al., 2017).
The strongest growth inhibition was observed for a B. velezensis isolate; however, the vitality of the H. fraxineus mycelium was not substantially altered. On the other hand, the strong fungistatic effect might be sufficient to prevent the spread of the pathogen in ash leaves. B. velezensis is known to possess antagonistic activity toward various phytopathogenic fungi by producing antifungal compounds, such as bacillomycin, fengycin, and iturin (Palazzini et al., 2016; Lim et al., 2017). In tomato, Elsayed et al. (2020) showed a shift in the composition of the prokaryotic community in response to inoculation with B. velezensis and assumed a priming effect of plant defenses against the pathogen Ralstonia solanacearum.
In vitro screens for antagonism with dual cultures are a promising method to search for potential biocontrol candidates that directly affect the respective fungal pathogen. However, niche competition, blocking potential entry points of the pathogen, and indirectly activating the plant immune system also lead to a higher tolerance of the host plant (van Loon et al., 2008; Berg et al., 2017; Terhonen et al., 2018). Thus, non-antagonistic bacteria are important in plant defenses as well (De Boer et al., 2006; Ardanov et al., 2012; Ab Rahman et al., 2018). In recent years, inoculation with individual bacterial isolates has been shown to trigger a shift in the plant microbiome (Andreote et al., 2010; Mitter et al., 2017). According to Ardanov et al. (2012), an endophytic Methylobacterium isolate shifts the structure of the entire endophytic community in potato plants. The alteration in the microbiome correlated with the resistance to different pathogens, whereas the bacterium itself did not possess antagonistic activity.
In conclusion, the study of the ash phyllosphere resulted in the identification of bacteria specific to healthy leaves and confirmed the hypothesis that significant differences exist in a series of bacterial groups putatively capable of suppressing disease progression. This result was completed by a set of isolates that substantially inhibited H. fraxineus growth in vitro. The bacteria were isolated directly from ash leaves, wherefore it can be assumed that they are able to stably establish after inoculation of F. excelsior seedlings. In a next step, in planta experiments over a longer period of exposure to H. fraxineus are required to evaluate the isolates or consortia of isolates, acting via direct antagonism or competition or indirectly via induction of resistance.
Statements
Data availability statement
The datasets generated for this study can be found in the Sequence Read Archive (SRA): PRJNA602193, NCBI: MN989032–MN989182.
Author contributions
KU and RB performed the experiments, analyzed the data, and prepared the manuscript. UB performed the MALDI-TOF manuscript analysis. KU, MK, and AU conducted the microbiome analysis. All authors listed substantially contributed to and approved the manuscript. AU and MK supervised the entire study.
Funding
This study was supported by grant 22006116 from the Fachagentur Nachwachsende Rohstoffe (FNR), Germany.
Acknowledgments
We thank our colleagues from the forest district Lendershagen, as well as Ben Bubner, Volker Schneck, and Falk Schäfer for monitoring the ash plots and their assistance with the sampling campaign. We are grateful to Ulrike Klauß, Heidrun Mattauch, and Sigune Weinert for providing excellent technical assistance.
Conflict of interest
The authors declare that the research was conducted in the absence of any commercial or financial relationships that could be construed as a potential conflict of interest.
Supplementary material
The Supplementary Material for this article can be found online at: https://www.frontiersin.org/articles/10.3389/fmicb.2020.00966/full#supplementary-material
References
1
Ab RahmanS. F. S.SinghE.PieterseC. M. J.SchenkP. M. (2018). Emerging microbial biocontrol strategies for plant pathogens.Plant Sci.267102–111. 10.1016/j.plantsci.2017.11.012
2
AnderssonP. F.JohanssonS. B. K.StenlidJ.BrobergA. (2010). Isolation, identification and necrotic activity of viridiol from Chalara fraxinea, the fungus responsible for dieback of ash.Forest Pathol.4043–46. 10.1111/j.1439-0329.2009.00605.x
3
AndreoteF. D.da RochaU. N.AraujoW. L.AzevedoJ. L.van OverbeekL. S. (2010). Effect of bacterial inoculation, plant genotype and developmental stage on root-associated and endophytic bacterial communities in potato (Solanum tuberosum).Anton Leeuw Int. J. G.97389–399. 10.1007/s10482-010-9421-9
4
ArdanovP.SessitschA.HaggmanH.KozyrovskaN.PirttilaA. M. (2012). Methylobacterium-induced endophyte community changes correspond with protection of plants against pathogen attack.PLoS One7:e46802. 10.1371/journal.pone.0046802
5
AydoganE. L.MoserG.MullerC.KampferP.GlaeserS. P. (2018). Long-term warming shifts the composition of bacterial communities in the phyllosphere of Galium album in a permanent grassland field-experiment.Front. Microbiol.9:144. 10.3389/fmicb.2018.00144
6
BakkerP. A. H. M.PieterseC. M. J.van LoonL. C. (2007). Induced systemic resistance by fluorescent Pseudomonas spp.Phytopathology97239–243. 10.1094/Phyto-97-2-0239
7
BaralH.-O.QuelozV.HosoyaT. (2014). Hymenoscyphus fraxineus, the correct scientific name for the fungus causing ash dieback in Europe.IMA Fungus579–80. 10.5598/imafungus.2014.05.01.09
8
BarriusoJ.SolanoB. R.SantamariaC.DazaA.ManeroF. J. G. (2008). Effect of inoculation with putative plant growth-promoting rhizobacteria isolated from Pinus spp. on Pinus pinea growth, mycorrhization and rhizosphere microbial communities.J. Appl. Microbiol.1051298–1309. 10.1111/j.1365-2672.2008.03862.x
9
BergG.KoberlM.RybakovaD.MullerH.GroschR.SmallaK. (2017). Plant microbial diversity is suggested as the key to future biocontrol and health trends.FEMS Microbiol. Ecol.93:fix050. 10.1093/femsec/fix050
10
BloembergG. V.LugtenbergB. J. (2001). Molecular basis of plant growth promotion and biocontrol by rhizobacteria.Curr. Opin. Plant Biol.4343–350. 10.1016/s1369-5266(00)00183-7
11
BorahM.DasS.BaruahH.BoroR. C.BarooahM. (2018). Diversity of culturable endophytic bacteria from wild and cultivated rice showed potential plant growth promoting activities.bioRxiv [Preprint]. 10.1101/310797
12
BrooksD. S.GonzalezC. F.AppelD. N.FilerT. H. (1994). Evaluation of endophytic bacteria as potential biological-control agents for oak wilt.Biol. Control4373–381. 10.1006/bcon.1994.1047
13
BullingtonL. S.LekbergY.SniezkoR.LarkinB. (2018). The influence of genetics, defensive chemistry and the fungal microbiome on disease outcome in whitebark pine trees.Mol. Plant Pathol.191847–1858. 10.1111/mpp.12663
14
CallahanB. J.McMurdieP. J.HolmesS. P. (2017). Exact sequence variants should replace operational taxonomic units in marker-gene data analysis.ISME J.112639–2643. 10.1038/ismej.2017.119
15
ChaiharnM.ChunhaleuchanonS.LumyongS. (2009). Screening siderophore producing bacteria as potential biological control agent for fungal rice pathogens in Thailand.World J. Microbiol. Biotechnol.251919–1928. 10.1007/s11274-009-0090-7
16
ChandelierA.GerartsF.San MartinG.HermanM.DelahayeL. (2016). Temporal evolution of collar lesions associated with ash dieback and the occurrence of Armillaria in Belgian forests.Forest Pathol.46289–297. 10.1111/efp.12258
17
ChandelierA.HelsonM.DvorakM.GischerF. (2014). Detection and quantification of airborne inoculum of Hymenoscyphus pseudoalbidus using real-time PCR assays.Plant Pathol.631296–1305. 10.1111/ppa.12218
18
CheliusM. K.TriplettE. W. (2001). The diversity of archaea and bacteria in association with the roots of Zea mays L.Microb. Ecol.41252–263. 10.1007/s002480000087
19
ChongJ.LiuP.ZhouG.XiaJ. (2020). Using microbiomeanalyst for comprehensive statistical, functional, and meta-analysis of microbiome data.Nat. Protoc.15799–821. 10.1038/s41596-019-0264-1
20
ChunJ. S.GoodfellowM. (1995). A phylogenetic analysis of the genus Nocardia with 16S ribosomal RNA gene-sequences.Int. J. Syst. Bacteriol.45240–245. 10.1099/00207713-45-2-240
21
ChungY. R.KimC. H.HwangI.ChunJ. (2000). Paenibacillus koreensis sp nov., a new species that produces an iturin-like antifungal compound.Int. J. Syst. Evol. Microbiol.501495–1500. 10.1099/00207713-50-4-1495
22
ClearyM.NguyenD.MarciulynieneD.BerlinA.VasaitisR.StenlidJ. (2016). Friend or foe? Biological and ecological traits of the European ash dieback pathogen Hymenoscyphus fraxineus in its native environment.Sci. Rep.6:21895. 10.1038/srep21895
23
ClearyM. R.DanielG.StenlidJ. (2013). Light and scanning electron microscopy studies of the early infection stages of Hymenoscyphus pseudoalbidus on Fraxinus excelsior.Plant Pathol.621294–1301. 10.1111/ppa.12048
24
CombyM.GacoinM.RobineauM.RabenoelinaF.PtasS.DupontJ.et al (2017). Screening of wheat endophytes as biological control agents against Fusarium head blight using two different in vitro tests.Microbiol. Res.20211–20. 10.1016/j.micres.2017.04.014
25
CompantS.DuffyB.NowakJ.ClémentC.BarkaE. A. (2005). Use of plant growth-promoting bacteria for biocontrol of plant diseases: principles, mechanisms of action, and future prospects.Appl. Environ. Microbiol.714951–4959. 10.1128/aem.71.9.4951-4959.2005
26
CompantS.SamadA.FaistH.SessitschA. (2019). A review on the plant microbiome: ecology, functions, and emerging trends in microbial application.J. Adv. Res.1929–37. 10.1016/j.jare.2019.03.004
27
CrombieA. T.Larke-MejiaN. L.EmeryH.DawsonR.PratscherJ.MurphyG. P.et al (2018). Poplar phyllosphere harbors disparate isoprene-degrading bacteria.Proc. Natl. Acad. Sci. U.S.A.11513081–13086. 10.1073/pnas.1812668115
28
CrossH.SonsteboJ. H.NagyN. E.TimmermannV.SolheimH.BorjaI.et al (2017). Fungal diversity and seasonal succession in ash leaves infected by the invasive ascomycete Hymenoscyphus fraxineus.New Phytol.2131405–1417. 10.1111/nph.14204
29
DavydenkoK.VasaitisR.StenlidJ.MenkisA. (2013). Fungi in foliage and shoots of Fraxinus excelsior in eastern Ukraine: a first report on Hymenoscyphus pseudoalbidus.Forest Pathol.43462–467. 10.1111/efp.12055
30
De BoerW.WagenaarA. M.Klein GrunnewiekP. J. A.van VeenJ. A. (2006). In vitro suppression of fungi caused by combinations of apparently non-antagonistic soil bacteria.FEMS Microbiol. Ecol.59177–185.
31
DrenkhanR.SolheimH.BogachevaA.RiitT.AdamsonK.DrenkhanT.et al (2017). Hymenoscyphus fraxineus is a leaf pathogen of local Fraxinus species in the Russian Far East.Plant Pathol.66490–500. 10.1111/ppa.12588
32
ElsayedT. R.JacquiodS.NourE. H.SørensenS. J.SmallaK. (2020). Biocontrol of bacterial wilt disease through complex interaction between tomato plant, antagonists, the indigenous rhizosphere microbiota, and Ralstonia solanacearum.Front. Microbiol.10:2835. 10.3389/fmicb.2019.02835
33
EmmertE. A.HandelsmanJ. (1999). Biocontrol of plant disease: a (gram-) positive perspective.FEMS Microbiol. Lett.1711–9. 10.1111/j.1574-6968.1999.tb13405.x
34
FouziaA.AllaouaS.HafsaC. S.MostefaG. (2015). Plant growth promoting and antagonistic traits of indigenous fluorescent Pseudomonas spp. isolated from wheat rhizosphere and A. halimus endosphere.Eur. Sci. J.11129–148.
35
FrickerA. M.PodlesnyD.FrickeW. F. (2019). What is new and relevant for sequencing-based microbiome research? A mini-review.J. Adv. Res.19105–112. 10.1016/j.jare.2019.03.006
36
GonzálezR.MendozaR.PérezV.SolerA. (2017). “Evaluation of the antimicrobial activity of endogenous bacteria against Phytophthora nicotianae,” in Proceedings of the Congreso International de Biotecnologia Vegetal, Ciego de Avila.
37
GradyE. N.MacDonaldJ.LiuL.RichmanA.YuanZ.-C. (2016). Current knowledge and perspectives of Paenibacillus: a review.Microb. Cell Fact.15203–203. 10.1186/s12934-016-0603-7
38
GriffithsS. M.GalambaoM.RowntreeJ. K.GoodheadI.HallJ.O’BrienD.et al (2020). Complex associations between cross-kingdom microbial endophytes and host genotype in ash dieback disease dynamics.J. Ecol.108291–309. 10.1111/1365-2745.13302
39
GrossA.HoldenriederO.PautassoM.QuelozV.SieberT. N. (2014). Hymenoscyphus pseudoalbidus, the causal agent of European ash dieback.Mol. Plant Pathol.155–21. 10.1111/mpp.12073
40
GrossA.ZaffaranoP. L.DuoA.GrunigC. R. (2012). Reproductive mode and life cycle of the ash dieback pathogen Hymenoscyphus pseudoalbidus.Fungal Genet. Biol.49977–986. 10.1016/j.fgb.2012.08.008
41
HaasD.DefagoG. (2005). Biological control of soil-borne pathogens by fluorescent pseudomonads.Nat. Rev. Microbiol.3307–319. 10.1038/nrmicro1129
42
HaleckerS.SurupF.KuhnertE.MohrK. I.BrockN. L.DickschatJ. S.et al (2014). Hymenosetin, a 3-decalinoyltetramic acid antibiotic from cultures of the ash dieback pathogen, Hymenoscyphus pseudoalbidus.Phytochemistry10086–91. 10.1016/j.phytochem.2014.01.018
43
HamontsK.TrivediP.GargA.JanitzC.GrinyerJ.HolfordP.et al (2018). Field study reveals core plant microbiota and relative importance of their drivers.Environ. Microbiol.20124–140. 10.1111/1462-2920.14031
44
HanackovaZ.HavrdovaL.CernyK.ZahradnikD.KoukolO. (2017a). Fungal endophytes in ash shoots - diversity and inhibition of Hymenoscyphus fraxineus.Baltic Forest.2389–106.
45
HanackovaZ.KoukolO.CmokovaA.ZahradnikD.HavrdovaL. (2017b). Direct evidence of Hymenoscyphus fraxineus infection pathway through the petiole-shoot junction.Forest Pathol.47:12370. 10.1111/efp.12370
46
HardoimP. R.van OverbeekL. S.BergG.PirttilaA. M.CompantS.CampisanoA.et al (2015). The hidden world within plants: ecological and evolutionary considerations for defining functioning of microbial endophytes.Microbiol. Mol. Biol. Rev.79293–320. 10.1128/Mmbr.00050-14
47
HardoimP. R.van OverbeekL. S.van ElsasJ. D. (2008). Properties of bacterial endophytes and their proposed role in plant growth.Trends Microbiol.16463–471. 10.1016/j.tim.2008.07.008
48
HietalaA. M.TimmermannV.BorjaI.SolheimH. (2013). The invasive ash dieback pathogen Hymenoscyphus pseudoalbidus exerts maximal infection pressure prior to the onset of host leaf senescence.Fungal Ecol.6302–308. 10.1016/j.funeco.2013.03.008
49
HuschekD.WitzelK. (2019). Rapid dereplication of microbial isolates using matrix-assisted laser desorption ionization time-of-flight mass spectrometry: a mini-review.J. Adv. Res.1999–104. 10.1016/j.jare.2019.03.007
50
JakuschkinB.FievetV.SchwallerL.FortT.RobinC.VacherC. (2016). Deciphering the pathobiome: intra- and interkingdom interactions involving the pathogen Erysiphe alphitoides.Microb. Ecol.72870–880. 10.1007/s00248-016-0777-x
51
JunkerC. (2013). Pathogenese und Ansätze zur Kontrolle von Hymenoscyphus Pseudoalbidus – Erreger der Eschentriebsterbens: Variabilität Von Virulenz, Morphologie, Biochemie und Sekundärstoffwechsel.Dissertation. Available online at: http://www.digibib.tu-bs.de/?docid=00054026(accessed May 19, 2020).
52
JunkerC.de VriesJ.EickhorstC.SchulzB. (2017). Each isolate of Hymenoscyphus fraxineus is an individualist as shown by exoenzyme and growth rate profiles.Balt. Forest2325–40.
53
KloepperJ. W.RyuC. M.ZhangS. A. (2004). Induced systemic resistance and promotion of plant growth by Bacillus spp.Phytopathology941259–1266. 10.1094/Phyto.2004.94.11.1259
54
KöberlM.DitaM.MartinuzA.StaverC.BergG. (2017). Members of Gammaproteobacteria as indicator species of healthy banana plants on Fusarium wilt-infested fields in Central America.Sci. Rep.7:45318. 10.1038/srep45318
55
KosawangC.AmbyD. B.BussabanB.McKinneyL. V.XuJ.KjaerE. D.et al (2018). Fungal communities associated with species of Fraxinus tolerant to ash dieback, and their potential for biological control.Fungal Biol.122110–120. 10.1016/j.funbio.2017.11.002
56
KosawangC.SorensenH.KjaerE. D.DilokpimolA.McKinneyL. V.CollingeD. B.et al (2019). Defining the twig fungal communities of Fraxinus species and Fraxinus excelsior genotypes with differences in susceptibility to ash dieback.Fungal Ecol.42:100859. 10.1016/j.funeco.2019.08.003
57
KoskellaB.MeadenS.CrowtherW. J.LeimuR.MetcalfC. J. E. (2017). A signature of tree health? Shifts in the microbiome and the ecological drivers of horse chestnut bleeding canker disease.New Phytol.215737–746. 10.1111/nph.14560
58
KowalskiT.HoldenriederO. (2009a). Pathogenicity of Chalara fraxinea.Forest Pathol.391–7. 10.1111/j.1439-0329.2008.00565.x
59
KowalskiT.HoldenriederO. (2009b). The teleomorph of Chalara fraxinea, the causal agent of ash dieback.Forest Pathol.39304–308. 10.1111/j.1439-0329.2008.00589.x
60
Laforest-LapointeI.MessierC.KembelS. W. (2016). Tree phyllosphere bacterial communities: exploring the magnitude of intra- and inter-individual variation among host species.PeerJ4:e2367. 10.7717/peerj.2367
61
LaneD. J. (1991). “16S/23S rRNA sequencing,” in Nucleic Acid Techniques in Bacterial Systematics, edsStackebrandtE.GoodfellowM. (Chichester: John Wiley and Sons), 115–175.
62
LangerG.HarriehausenU.BressemU. (2015). Stammfußnekrosen bei Esche.AFZ Der Wald2029–31.
63
LemanceauP.BlouinM.MullerD.Moenne-LoccozY. (2017). Let the core microbiota be functional.Trends Plant Sci.22583–595. 10.1016/j.tplants.2017.04.008
64
LeveauJ. H. J.TechJ. J. (2011). Grapevine microbiomics: bacterial diversity on grape leaves and berries revealed by high-throughput sequence analysis of 16S rRNA amplicons.Acta Hortic.90531–42.
65
LimS. M.YoonM.-Y.ChoiG. J.ChoiY. H.JangK. S.ShinT. S.et al (2017). Diffusible and volatile antifungal compounds produced by an antagonistic Bacillus velezensis G341 against various phytopathogenic fungi.Plant Pathol. J.33488–498. 10.5423/PPJ.OA.04.2017.0073
66
LinS. Y.HameedA.LiuY. C.HsuY. H.LaiW. A.ShenF. T.et al (2013). Aureimonas ferruginea sp. nov and Aureimonas rubiginis sp. nov., two siderophore-producing bacteria isolated from rusty iron plates.Int. J. Syst. Evol. Microbiol.632430–2435. 10.1099/ijs.0.047431-0
67
LiuW. T.MarshT. L.ChengH.ForneyL. J. (1997). Characterization of microbial diversity by determining terminal restriction fragment length polymorphisms of genes encoding 16S rRNA.Appl. Environ. Microbiol.634516–4522.
68
MansfieldJ. W.GalambosN.SavilleR. (2018). The use of ascospores of the dieback fungus Hymenoscyphus fraxineus for infection reveals a period of biotrophic interaction in penetrated ash cells.Phytopathology10826–26.
69
MavrodiD. V.BlankenfeldtW.ThomashowL. S. (2006). Phenazine compounds in fluorescent Pseudomonas spp. biosynthesis and regulation.Annu. Rev. Phytopathol.44417–445. 10.1146/annurev.phyto.44.013106.145710
70
McKinneyL. V.NielsenL. R.CollingeD. B.ThomsenI. M.HansenJ. K.KjaerE. D. (2014). The ash dieback crisis: genetic variation in resistance can prove a long-term solution.Plant Pathol.63485–499. 10.1111/ppa.12196
71
MelnickR. L.SuarezC.BaileyB. A.BackmanP. A. (2011). Isolation of endophytic endospore-forming bacteria from Theobroma cacao as potential biological control agents of cacao diseases.Biol. Control57236–245. 10.1016/j.biocontrol.2011.03.005
72
MitterB.PfaffenbichlerN.FlavellR.CompantS.AntonielliL.PetricA.et al (2017). A new approach to modify plant microbiomes and traits by introducing beneficial bacteria at flowering into progeny seeds.Front. Microbiol.8:11. 10.3389/fmicb.2017.00011
73
MuletM.LalucatJ.García-ValdésE. (2010). DNA sequence-based analysis of the Pseudomonas species.Environ. Microbiol.121513–1530. 10.1111/j.1462-2920.2010.02181.x
74
MullerD. B.VogelC.BaiY.VorholtJ. A. (2016). The plant microbiota: systems-level insights and perspectives.Annu. Rev. Genet.50211–234. 10.1146/annurev-genet-120215-034952
75
MüllerH.BergC.LandaB. B.AuerbachA.Moissl-EichingerC.BergG. (2015). Plant genotype-specific archaeal and bacterial endophytes but similar Bacillus antagonists colonize Mediterranean olive trees.Front. Microbiol.6:138. 10.3389/Fmicb.2015.00138
76
MüllerT.BehrendtU.RuppelS.von, der WaydbrinkG.MüllerM. E. H. (2016). Fluorescent pseudomonads in the phyllosphere of wheat: potential antagonists against fungal phytopathogens.Curr. Microbiol.72383–389. 10.1007/s00284-015-0966-8
77
NaingK. W.AneesM.KimS. J.NamY.KimY. C.KimK. Y. (2014). Characterization of antifungal activity of Paenibacillus ehimensis KWN38 against soilborne phytopathogenic fungi belonging to various taxonomic groups.Ann. Microbiol.6455–63. 10.1007/s13213-013-0632-y
78
OngenaM.JacquesP.ToureY.DestainJ.JabraneA.ThonartP. (2005). Involvement of fengycin-type lipopeptides in the multifaceted biocontrol potential of Bacillus subtilis.Appl. Microbiol. Biotechnol.6929–38. 10.1007/s00253-005-1940-3
79
OngenaM.JourdanE.AdamA.PaquotM.BransA.JorisB.et al (2007). Surfactin and fengycin lipopeptides of Bacillus subtilis as elicitors of induced systemic resistance in plants.Environ. Microbiol.91084–1090. 10.1111/j.1462-2920.2006.01202.x
80
Orozco-MosquedaM. D.Rocha-GranadosM. D.GlickB. R.SantoyoG. (2018). Microbiome engineering to improve biocontrol and plant growth-promoting mechanisms.Microbiol. Res.20825–31. 10.1016/j.micres.2018.01.005
81
PalazziniJ. M.DunlapC. A.BowmanM. J.ChulzeS. N. (2016). Bacillus velezensis RC 218 as a biocontrol agent to reduce Fusarium head blight and deoxynivalenol accumulation: genome sequencing and secondary metabolite cluster profiles.Microbiol. Res.19230–36. 10.1016/j.micres.2016.06.002
82
PaneC.ZaccardelliM. (2015). Evaluation of Bacillus strains isolated from solanaceous phylloplane for biocontrol of Alternaria early blight of tomato.Biol. Control8411–18. 10.1016/j.biocontrol.2015.01.005
83
PaulsonJ. N.StineO. C.BravoH. C.PopM. (2013). Differential abundance analysis for microbial marker-gene surveys.Nat. Methods101200–1202. 10.1038/nmeth.2658
84
PeixA.Ramírez-BahenaM.-H.VelázquezE. (2018). The current status on the taxonomy of Pseudomonas revisited: an update.Infect. Genet. Evol.57106–116. 10.1016/j.meegid.2017.10.026
85
PrietoP.SchiliroE.Maldonado-GonzalezM. M.ValderramaR.Barroso-AlbarracinJ. B.Mercado-BlancoJ. (2011). Root hairs play a key role in the endophytic colonization of olive roots by Pseudomonas spp. with biocontrol activity.Microb. Ecol.62435–445. 10.1007/s00248-011-9827-6
86
PrzybylK. (2003). Effect of Pseudomonas spp. on inoculation of young plants of Fraxinus excelsior stem with Diplodia mutila.Dendrobiology5029–32.
87
QuelozV.GrunigC. R.BerndtR.KowalskiT.SieberT. N.HoldenriederO. (2011). Cryptic speciation in Hymenoscyphus albidus.Forest Pathol.41133–142. 10.1111/j.1439-0329.2010.00645.x
88
RaaijmakersJ. M.LeemanM.VanoorschotM. M. P.VandersluisI.SchippersB.BakkerP. A. H. M. (1995). Dose-response relationships in biological control of Fusarium-wilt of radish by Pseudomonas spp.Phytopathology851075–1081. 10.1094/Phyto-85-1075
89
RedfordA. J.BowersR. M.KnightR.LinhartY.FiererN. (2010). The ecology of the phyllosphere: geographic and phylogenetic variability in the distribution of bacteria on tree leaves.Environ. Microbiol.122885–2893. 10.1111/j.1462-2920.2010.02258.x
90
SangM. K.JeongJ. J.KimJ.KimK. D. (2018). Growth promotion and root colonisation in pepper plants by phosphate-solubilising Chryseobacterium sp. strain ISE14 that suppresses Phytophthora blight.Ann. Appl. Biol.172208–223. 10.1111/aab.12413
91
SangM. K.KimE. N.HanG. D.KwackM. S.JeunY. C.KimK. D. (2014). Priming-mediated systemic resistance in cucumber induced by Pseudomonas azotoformans GC-B19 and Paenibacillus elgii MM-B22 against Colletotrichum orbiculare.Phytopathology104834–842. 10.1094/Phyto-11-13-0305-R
92
SappM.LewisE.MossS.BarrettB.KirkS.ElphinstoneJ. G.et al (2016). Metabarcoding of bacteria associated with the acute oak decline syndrome in England.Forests7:95. 10.3390/f7050095
93
SchlechterR. O.MiebachM.Remus-EmsermannM. N. P. (2019). Driving factors of epiphytic bacterial communities: a review.J. Adv. Res.1957–65. 10.1016/j.jare.2019.03.003
94
SchlegelM.DubachV.von BuolL.SieberT. N. (2016). Effects of endophytic fungi on the ash dieback pathogen.FEMS Microbiol. Ecol.92:142. 10.1093/femsec/fiw142
95
SchlegelM.QuelozV.SieberT. N. (2018). The endophytic mycobiome of European ash and sycamore maple leaves - geographic patterns, host specificity and influence of ash dieback.Front. Microbiol.9:2345. 10.3389/fmicb.2018.02345
96
SchlossP. D.WestcottS. L.RyabinT.HallJ. R.HartmannM.HollisterE. B.et al (2009). Introducing mothur: open-source, platform-independent, community-supported software for describing and comparing microbial communities.Appl. Environ. Microbiol.757537–7541. 10.1128/Aem.01541-09
97
ScholtysikA.UnterseherM.OttoP.WirthC. (2013). Spatio-temporal dynamics of endophyte diversity in the canopy of European ash (Fraxinus excelsior).Mycol. Prog.12291–304. 10.1007/s11557-012-0835-9
98
SchulzB.HaasS.JunkerC.AndreeN.SchobertM. (2015). Fungal endophytes are involved in multiple balanced antagonisms.Curr Sci10939–45.
99
SchwandaK.KirisitsT. (2016). Pathogenicity of Hymenoscyphus fraxineus towards leaves of three European ash species: Fraxinus excelsior, Fangustifolia and Fornus.Plant Pathol.651071–1083. 10.1111/ppa.12499
100
SelimS.NegrelJ.GovaertsC.GianinazziS.van TuinenD. (2005). Isolation and partial characterization of antagonistic peptides produced by Paenibacillus sp strain B2 isolated from the Sorghum mycorrhizosphere.Appl. Environ. Microbiol.716501–6507. 10.1128/Aem.71.11.6501-6507.2005
101
ShannonP.MarkielA.OzierO.BaligaN. S.WangJ. T.RamageD.et al (2003). Cytoscape: a software environment for integrated models of biomolecular interaction networks.Genome Res.132498–2504. 10.1101/gr.1239303
102
SkovsgaardJ. P.ThomsenI. M.SkovgaardI. M.MartinussenT. (2010). Associations among symptoms of dieback in even-aged stands of ash (Fraxinus excelsior L.).Forest Pathol.407–18. 10.1111/j.1439-0329.2009.00599.x
103
SunZ. B.ZhangH.YuanX. F.WangY. X.FengD. M.WangY. H.et al (2012). Luteimonas cucumeris sp nov., isolated a from cucumber leaf.Int. J. Syst. Evol. Microbiol.622916–2920. 10.1099/ijs.0.037549-0
104
SündermannJ.JütteK. (2014). Eschentriebsterben – Forst- und holzwirtschaftliche Strategien Zum Umgang mit dem neuartigen Eschentriebsterben; Teilvorhaben 1: Nachhaltige Eschenholzproduktion Sowie Erprobung effizienter und bodenschonender Holzernteverfahren auf sensiblen Nassstandorten. Schlussbericht FNR-Verbundvorhaben 22007410. Available online at: https://www.fnr.de/index.php?id=11150&fkz=22007410(accessed May 19, 2020).
105
TerhonenE.KovalchukA.ZarsavA.AsiegbuF. O. (2018). “Biocontrol potential of forest tree endophytes,” in Endophytes of Forest Trees: Biology and Applications, edsPirttiläA. M.FrankA. C. (Cham: Springer International Publishing), 283–318.
106
TimmermannV.BørjaI.HietalaA. M.KirisitsT.SolheimH. (2011). Ash dieback: pathogen spread and diurnal patterns of ascospore dispersal, with special emphasis on Norway.EPPO Bull.4114–20. 10.1111/j.1365-2338.2010.02429.x
107
UlrichA.WirthS. (1999). Phylogenetic diversity and population densities of culturable cellulolytic soil bacteria across an agricultural encatchment.Microb. Ecol.37238–247. 10.1007/s002489900146
108
UnterseherM.ReiherA.FinstermeierK.OttoP.MorawetzW. (2007). Species richness and distribution patterns of leaf-inhabiting endophytic fungi in a temperate forest canopy.Mycol. Prog.6201–212. 10.1007/s11557-007-0541-1
109
van LoonL. C.BakkerP. A. H. M.van der HeijdtW. H. W.WendehenneD.PuginA. (2008). Early responses of tobacco suspension cells to rhizobacterial elicitors of induced systemic resistance.Mol. Plant Microb. Interact211609–1621. 10.1094/Mpmi-21-12-1609
110
van OverbeekL. S.SaikkonenK. (2016). Impact of bacterial-fungal interactions on the colonization of the endosphere.Trends Plant Sci.21230–242. 10.1016/j.tplants.2016.01.003
111
VanpeerR.NiemannG. J.SchippersB. (1991). Induced resistance and phytoalexin accumulation in biological-control of Fusarium-wilt of carnation by Pseudomonas sp strain WCS417r Phytopathology.Secience81728–734. 10.1094/Phyto-81-728
112
VasaitisR.EnderleR. (2017). Dieback of European Ash (Fraxinus spp.) - Consequences and Guidelines for Sustainable Management. The Report on European Cooperation in Science & Technology (COST) Action FP1103 FRAXBACK.Uppsala: Swedish University of Agricultural Sciences.
113
WemheuerF.KaiserK.KarlovskyP.DanielR.VidalS.WemheuerB. (2017). Bacterial endophyte communities of three agricultural important grass species differ in their response towards management regimes.Sci. Rep.7:40914. 10.1038/srep40914
114
WeyensN.TaghaviS.BaracT.van der LelieD.BouletJ.ArtoisT.et al (2009). Bacteria associated with oak and ash on a TCE-contaminated site: characterization of isolates with potential to avoid evapotranspiration of TCE.Environ. Sci. Pollut. Res.16830–843. 10.1007/s11356-009-0154-0
115
WhippsJ. M.HandP.PinkD.BendingG. D. (2008). Phyllosphere microbiology with special reference to diversity and plant genotype.J. Appl. Microbiol.1051744–1755. 10.1111/j.1365-2672.2008.03906.x
116
WitzellJ.MartinJ. A. (2018). “Endophytes and forest health,” in Endophytes of Forest Trees, edsPirttiläA. M.FrankC. (Berlin: Springer), 261–282.
117
WuQ.DouX.WangQ.GuanZ.CaiY.LiaoX. (2018). Isolation of β-1,3-glucanase-producing microorganisms from Poria cocos cultivation soil via molecular biology.Molecules23:1555. 10.3390/molecules23071555
118
YadavS.DubeyS. K. (2018). Cellulose degradation potential of Paenibacillus lautus strain BHU3 and its whole genome sequence.Bioresour. Technol.262124–131. 10.1016/j.biortech.2018.04.067
119
YoonS. H.HaS. M.KwonS.LimJ.KimY.SeoH.et al (2017). Introducing EzBioCloud: a taxonomically united database of 16S rRNA gene sequences and whole-genome assemblies.Int. J. Syst. Evol. Microbiol.671613–1617. 10.1099/ijsem.0.001755
120
ZhaoY. J.HosoyaT.BaralH. O.HosakaK.KakishimaM. (2013). Hymenoscyphus pseudoalbidus, the correct name for Lambertella albida reported from Japan.Mycotaxon12225–41. 10.5248/122.25
Summary
Keywords
ash dieback, Fraxinus excelsior, microbiota, antagonism, dual cultures, healthy core microbiome, phyllosphere
Citation
Ulrich K, Becker R, Behrendt U, Kube M and Ulrich A (2020) A Comparative Analysis of Ash Leaf-Colonizing Bacterial Communities Identifies Putative Antagonists of Hymenoscyphus fraxineus. Front. Microbiol. 11:966. doi: 10.3389/fmicb.2020.00966
Received
28 February 2020
Accepted
22 April 2020
Published
29 May 2020
Volume
11 - 2020
Edited by
Daguang Cai, University of Kiel, Germany
Reviewed by
Luciano Kayser Vargas, Secretaria Estadual da Agricultura, Pecuária e Irrigação, Brazil; Carolina Chiellini, University of Pisa, Italy
Updates
Copyright
© 2020 Ulrich, Becker, Behrendt, Kube and Ulrich.
This is an open-access article distributed under the terms of the Creative Commons Attribution License (CC BY). The use, distribution or reproduction in other forums is permitted, provided the original author(s) and the copyright owner(s) are credited and that the original publication in this journal is cited, in accordance with accepted academic practice. No use, distribution or reproduction is permitted which does not comply with these terms.
*Correspondence: Andreas Ulrich, aulrich@zalf.de
This article was submitted to Plant Microbe Interactions, a section of the journal Frontiers in Microbiology
Disclaimer
All claims expressed in this article are solely those of the authors and do not necessarily represent those of their affiliated organizations, or those of the publisher, the editors and the reviewers. Any product that may be evaluated in this article or claim that may be made by its manufacturer is not guaranteed or endorsed by the publisher.